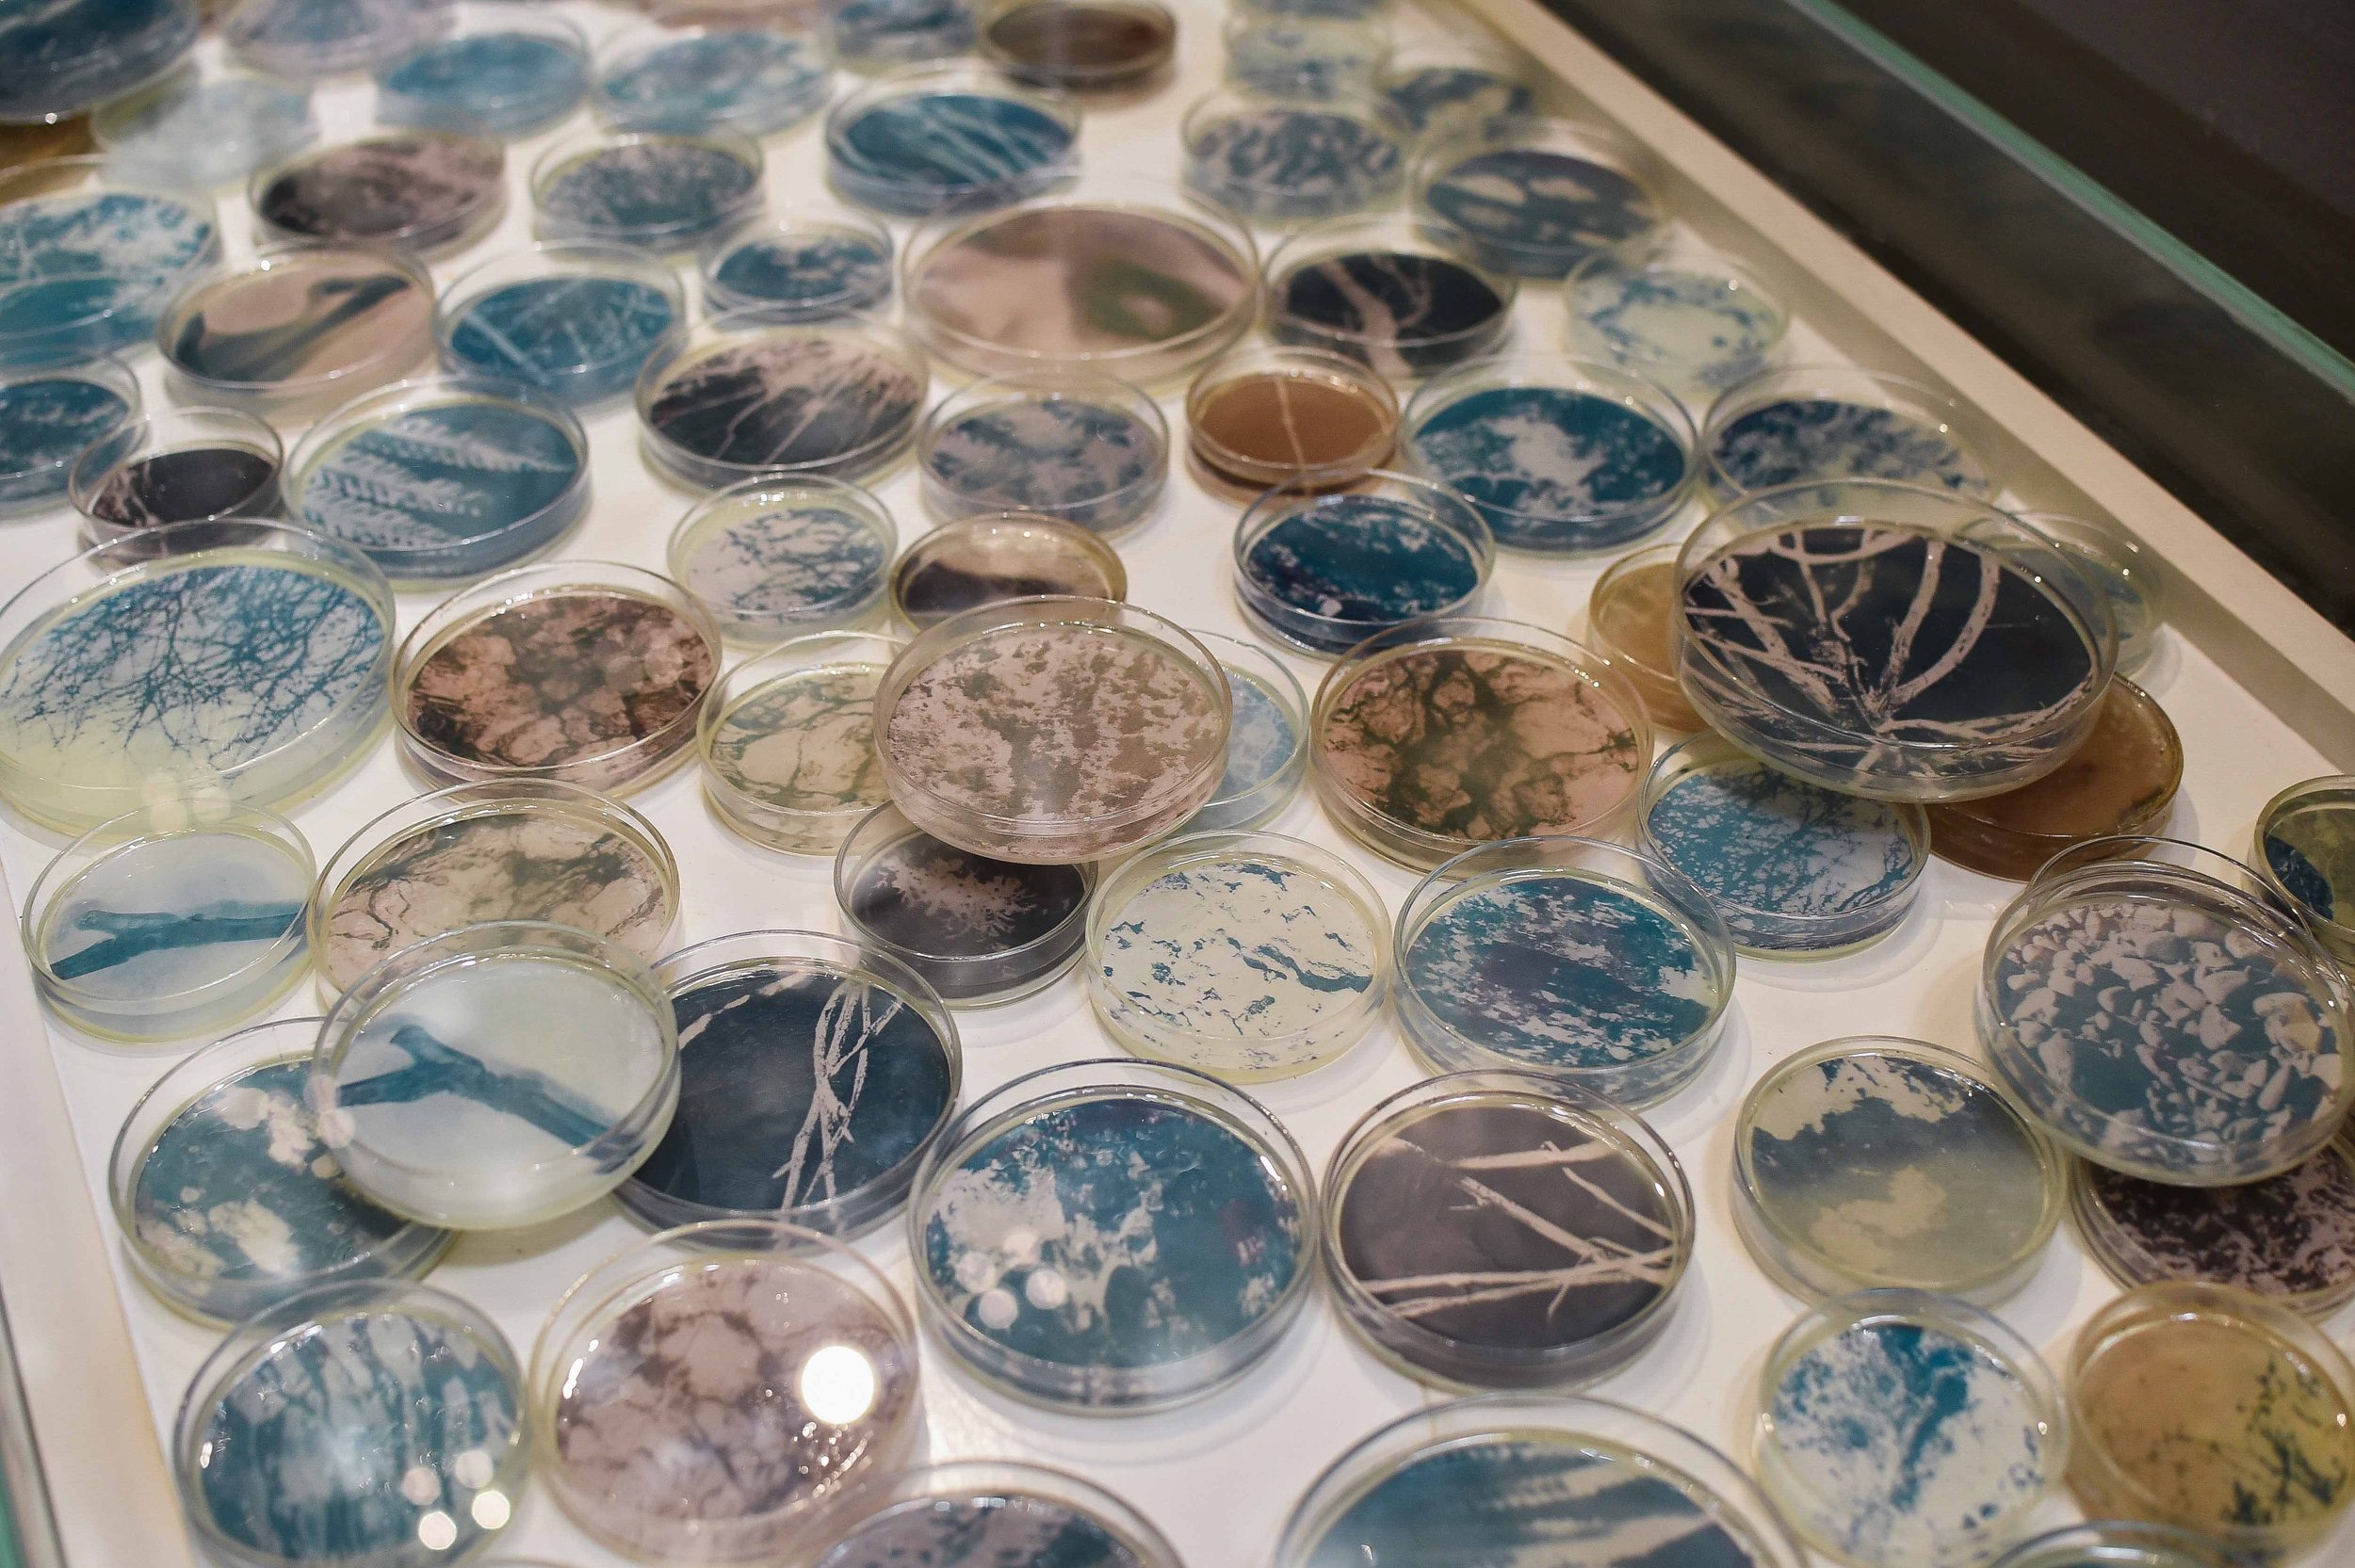

Ateneo Art Awards Returns to Recognize Creative Voices
Ateneo Art Awards and Ateneo Art Gallery are back to recognize the power and influence of local visual artists and writers in the Philippine art landscape.
Words Luis Joaquin Gregorio
Photo courtesy of Ateneo Art Awards
August 29, 2025
The much-anticipated shortlist for the Ateneo Art Awards 2025 has finally been released, featuring 12 visual artists competing for the Fernando Zóbel Prizes for Visual Art and 10 writers aiming to win the Purita Kalaw-Ledesma Prize for Art Criticism.
The list of participating artists was officially announced on August 19, 2025, at the Grand Atrium of Shangri-La Plaza.
Ateneo Art Awards 2025 Shortlisted Artists and Writers. Photo by Clefvan Pornela, coutesy of Ateneo Art Gallery.
The 12 artists who made the shortlist and are competing for the Fernando Zóbel Prizes for Visual Art are Lesley Ann-Cao, Urie de Ger, Lui Gonzales, Silke Lapina, Celline Marge Mercado, Hannah Reyes Morales, Veronica Peralejo, Issay Rodriguez, Eunice Sanchez, Jel Suarez, Vien Valencia, and Jezzel Wee.
The Ateneo Art Gallery will select four recipients of the Fernando Zóbel Prize from this group. Awardees will be honored with local and international residency grants, made possible through the support of the organization, artist communities, and external partners including ABungalow in Negros Occidental, CASA San Miguel in Zambales, La Trobe University - La Trobe Art Institute in Australia, Liverpool Hope University in United Kingdom, OCAD University in Canada, Project Space Pilipinas in Quezon Province, and new residency partners Koganecho Area Management Center in Japan, and Monsoon Southeast Asia in Singapore.
Installation shot of "Sa Ilog Nagtatagpo" of Ateneo Art Awards 2025 Shortlisted Artist Eunice Sanchez. Photo by Clefvan Pornela, courtesy of Ateneo Art Gallery (2025).
The partner hosts of the category will choose the recipient of the residency grant, while winning artists may also be selected by more than one residency host. Aside from this, one shortlisted artist will also be selected as the recipient of the Embassy of Italy Purchase Prize.
Meanwhile, the Purita Kalaw-Ledesma Prize is presented by the Kalaw-Ledesma Foundation and The Philippine Star, with entries divided into English and Filipino categories under the theme “Flight.” The shortlisted participants for the English category are Bea Belen-Ferrer, Abigail Buendia, Pie Tiausas, Tyra Maria Trono, and Denzel Yorong, while those competing in the Filipino category are Mavs Alviar, Emersan Baldemor, Eric Jhon Bituin, Josh Paradeza, and MJ Rafal.
Installation shot of "Between the Lines" of Ateneo Art Awards 2025 Shortlisted Artist Celline Marge Mercado. Photo by Clefvan Pornela, courtesy of Ateneo Art Gallery (2025).
The Philippine Star and ArtAsiaPacific will each select one winning writer from the English category, while Katipunan Journal will name one winner from the Filipino category. Recipients of the Purita Kalaw-Ledesma Prize will be invited to contribute to their respective publication partners and will receive month-long residency grants with Orange Project Naranja Residency in Negros Occidental, The White House in Zambales, and a new residency partner Indeks in Indonesia.
The skillful works of the shortlisted artists will be on view in their full glory at the Ateneo Art Gallery exhibition, running from September until December 7, 2025. The Awarding Ceremony will take place on October 5, 2025, at 2:00 PM, also at the Ateneo Art Gallery.